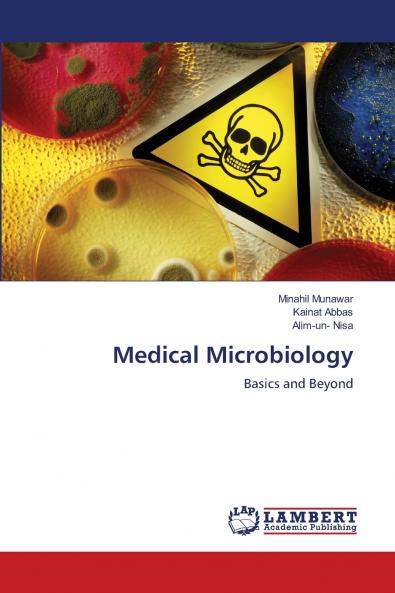
Medical Microbiology

English
Paperback
₹8060
₹10638
24.23% OFF
(All inclusive*)
Delivery Options
Please enter pincode to check delivery time.
*COD & Shipping Charges may apply on certain items.
Review final details at checkout.
Looking to place a bulk order? SUBMIT DETAILS
Delivery Options
Please enter pincode to check delivery time.
*COD & Shipping Charges may apply on certain items.
Review final details at checkout.
About The Book
Description
Author(s)
Medical microbiology is a branch of microbiology concerned with the study of microorganisms that cause diseases in humans including bacteriology virology mycology and parasitology. It is concerned with the biology of the pathogenic microbes methods and mechanisms of infections and of the immune response by the host diagnosis treatment methods and methods for disease prevention.
Details
ISBN 13
9786202434744
Publication Date
-11-09-2025
Pages
-108
Weight
-158 grams
Dimensions
-152x229x6.57 mm